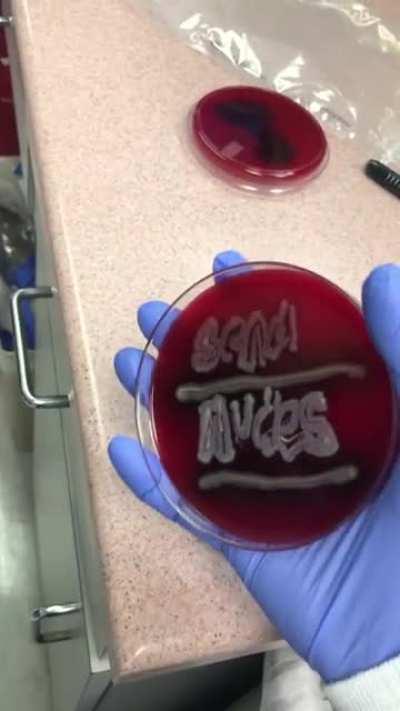
The kind of culture we deserve.

send_nudes
send_nudes
Browse Other Categories
- 4x4
- AutisticPilking
- casadepapel
- espectingSwings
- etibas
- JoJoClarkk
- krisstatlander69
- Lareinasworld
- laurenkellyharris
- Muse
- okbrodyretard
- otakuIndian
- Pyromania
- SecretHitler
- ShatteredPD
- SpawnCult
- spicylimedog
- SupremeShoelace
- thedivinity
- therealshuj0ka
- Touhou_Girls_Kissing
- u_lemme-find-out
- u_MisterSparkleRD
- u_Necessary-Ad2841
- wwolvesman